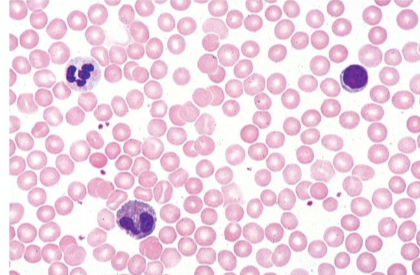
<p>what tissue is this</p>
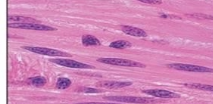
<p>what tissue is this</p>

1/107
Looks like no tags are added yet.
Name | Mastery | Learn | Test | Matching | Spaced | Call with Kai |
|---|
No analytics yet
Send a link to your students to track their progress

what phylum is this
zygomycetes
what is the common name for phylum Basidiomycota
club fungi
what phylum do morels belong too
ascomycota

what is this?
penicillium
what are the three germ layers
ectoderm, mesoderm, endoderm
protosome cleavage
spiral, determinate
deutersome cleavage
radial indeterminate
isolecithal eggs have ___________ cleavage
holoblastic (complete)
telolecithal eggs have _________ cleavage
meroblastic (incomplete)

“hollow” ball of cells is aka
blastula
isolecithal egg yolk is
evenly distributed
mesolecithal egg yolk is
concentrated in one area
what does gastrulation do
transforms the blastula into a gastrula with 3 germ layers
what is neurulation
the formation of the nervous system
what class are jawless fish
peromyzontoidea
what class are cartilagenous fish
chondrichthyes
what class are bony/ray-finned fish
actinopterygii
what class are amphibians
amphibia
what class are reptiles
reptilia
what class are birds
aves
what class are mammals
mammalia
functions of epithelial tissue
protection, absorption, secretion, filtration
characteristics of epithelial tissue
avascular, regenerative, polarity
one layer of epithelial tissue is called
simple
more than one layer of epithelial tissue is called
stratified

what shape of epithelial tissue is this
squamous

what shape of epithelial tissue is this
cuboidal

what shape of epithelial tissue is this
columnar
simple squamous epithelial tissue is located in
arteries/veins, lung
simple cuboidal epithelial tissue is located in
kidney
simple columnar epithelial tissue is located in
intestines
stratified squamous epithelial tissue is located in
esophagus
keratinized stratified squamous epithelial tissue is located in
skin

what tissue type is this
simple squamous epithelium

what tissue type is this
simple cuboidal epithelium

what tissue is this
simple columnar epithelium

what tissue is this
stratified squamous epithelium

what tissue is this
keratinized stratified squamous epithelium
what cells are present in columnar epithelium
goblet cells
what cells are located in connective tissue
fibroblasts
what are examples of loose connective tissue
adipose, areolar
what are examples of dense connective tissue
dermis
what are examples of supporting connective tissue
hyaline cartilage and bones
what are examples of fluid connective tissue
blood
what cells are in hyaline cartilage
chondrocytes
what cells are in bones
osteocytes
what is the matrix in hyaline cartilage called
lacunae

what tissue is this
areolar

what tissue is this
adipose

what tissue is this
dense connective tissue

what tissue is this
hyaline cartilage

what tissue is this
bone
what tissue is this
blood
characteristic of skeletal muscle
striations
characteristics of cardiac muscle
intercalated disks
where is smooth muscle located
around arteries and veins

what tissue is this
skeletal

what tissue is this
cardiac
what tissue is this
smooth

right atrium

left atrium

right ventricle

left ventricle
right atrioventricular valve aka
tricuspid
left atrioventricular valve aka
bicuspid or mitral

right AV/tricuspid valve

left AV/bicuspid vave

pulmonary semilunar valve

aortic semilunar valve

aorta

pulmonary artery

superior vena cava

inferior vena cava

left pulmonary veins

right pulmonary veins

label A
corpus callosum

label B
cerebral cortex

label c
cerebellum

label d
medulla oblongata

label E
amygdala

Label F
thalamus

Label G
basal ganglia

Identify A
vitreous chamber

identify b
lens

identify c
cornea

identify d
iris

identify e
pupil

identify f
cilliary body

identify g
optic nerve

identify h
retina

identify i
choroid

identify J
sclera
what is the refelctive structure in the sheep eye?
tapetum lucidum
what is the multicellular body of fungi called?
mycelium
what are mycelium composed of?
hyphae
what is plasmogamy
the fusion of cytoplasm of two haploid fungal cells
heterokaryotic
contains two or more genetically different nuclei in the same cytoplasm
dikaryotic
a cell that contains only 2 distinct nuclei
what are the key reproductive strucutres in phylum zygoycetes?
zygosporangia/zygospores
what is the key reproductive structure in phylum basidomycota?
basidia